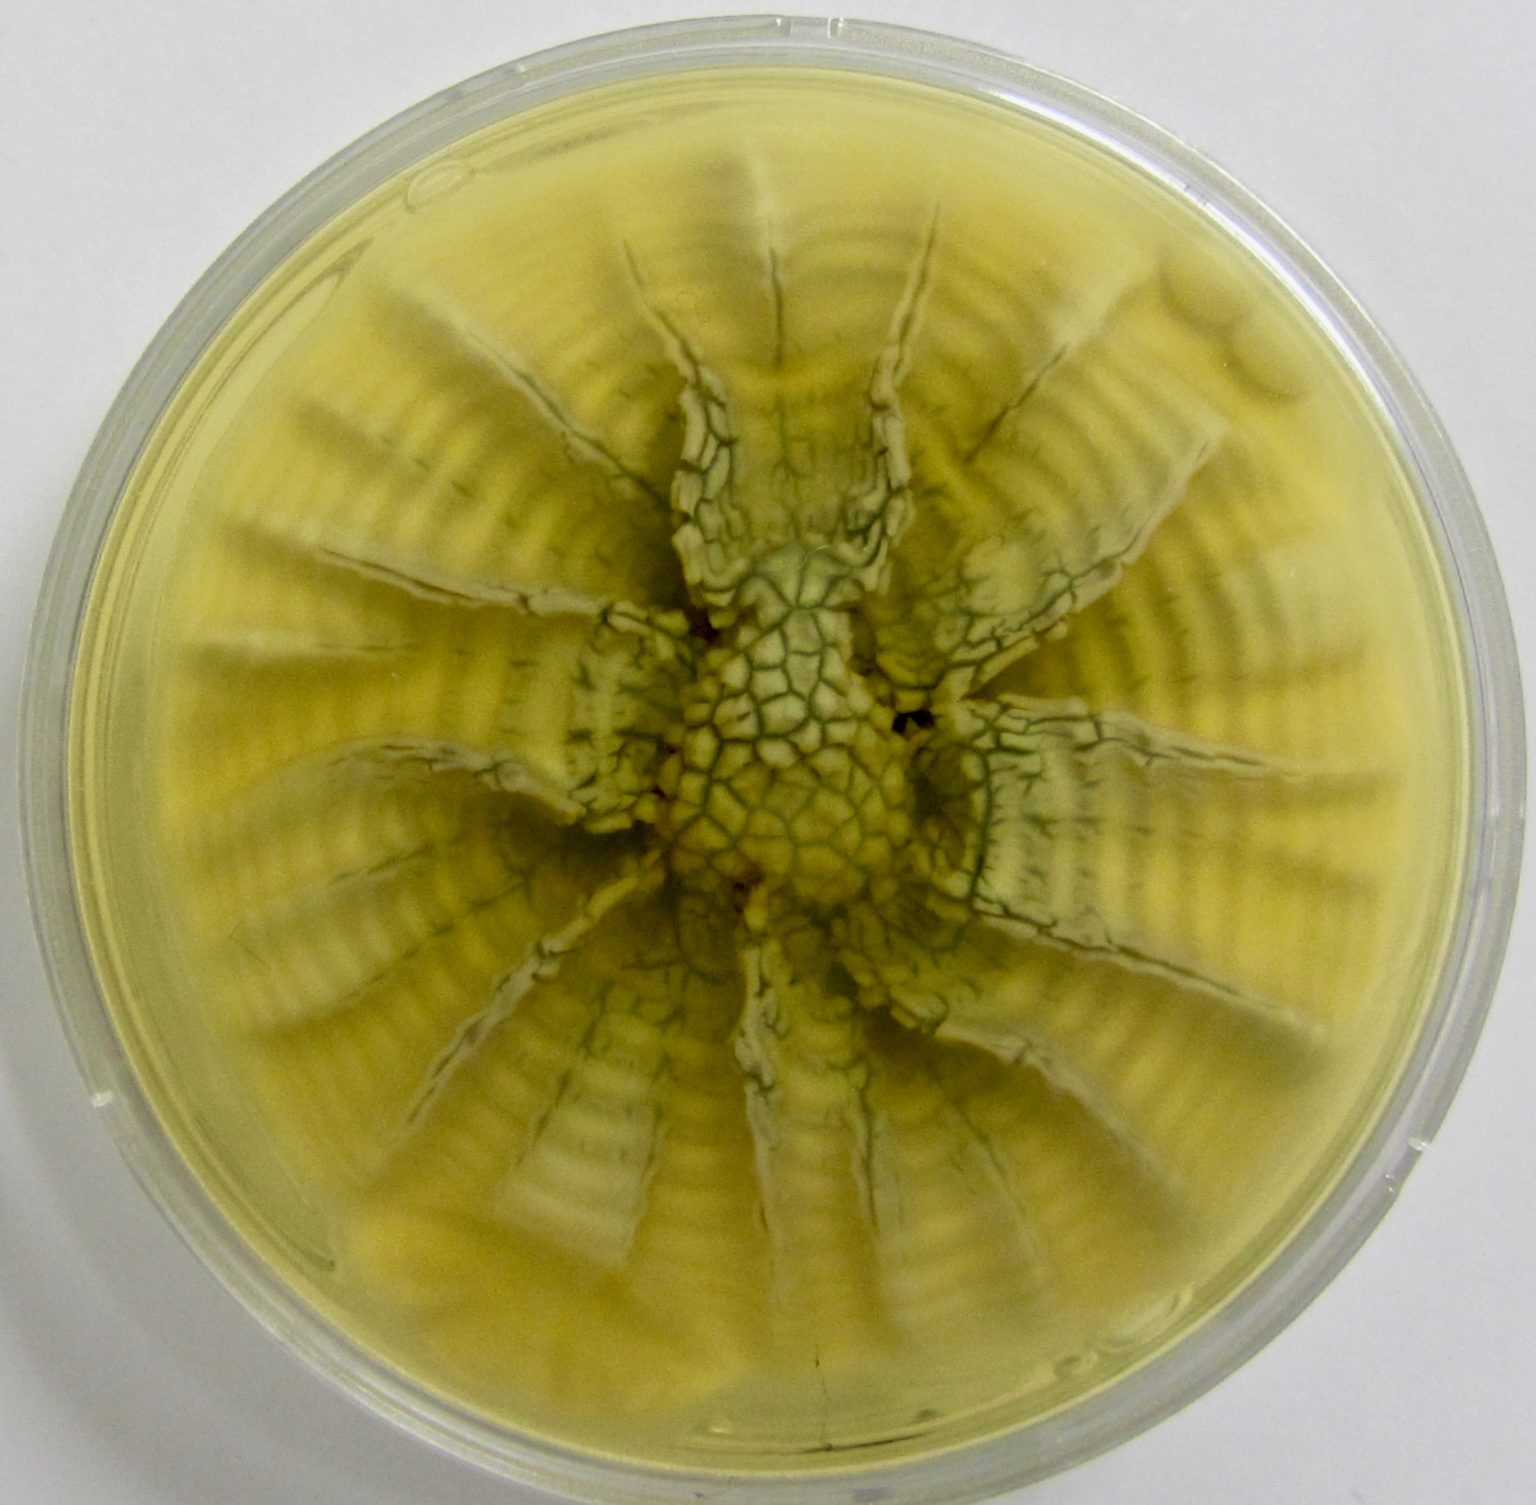
Image descriptive
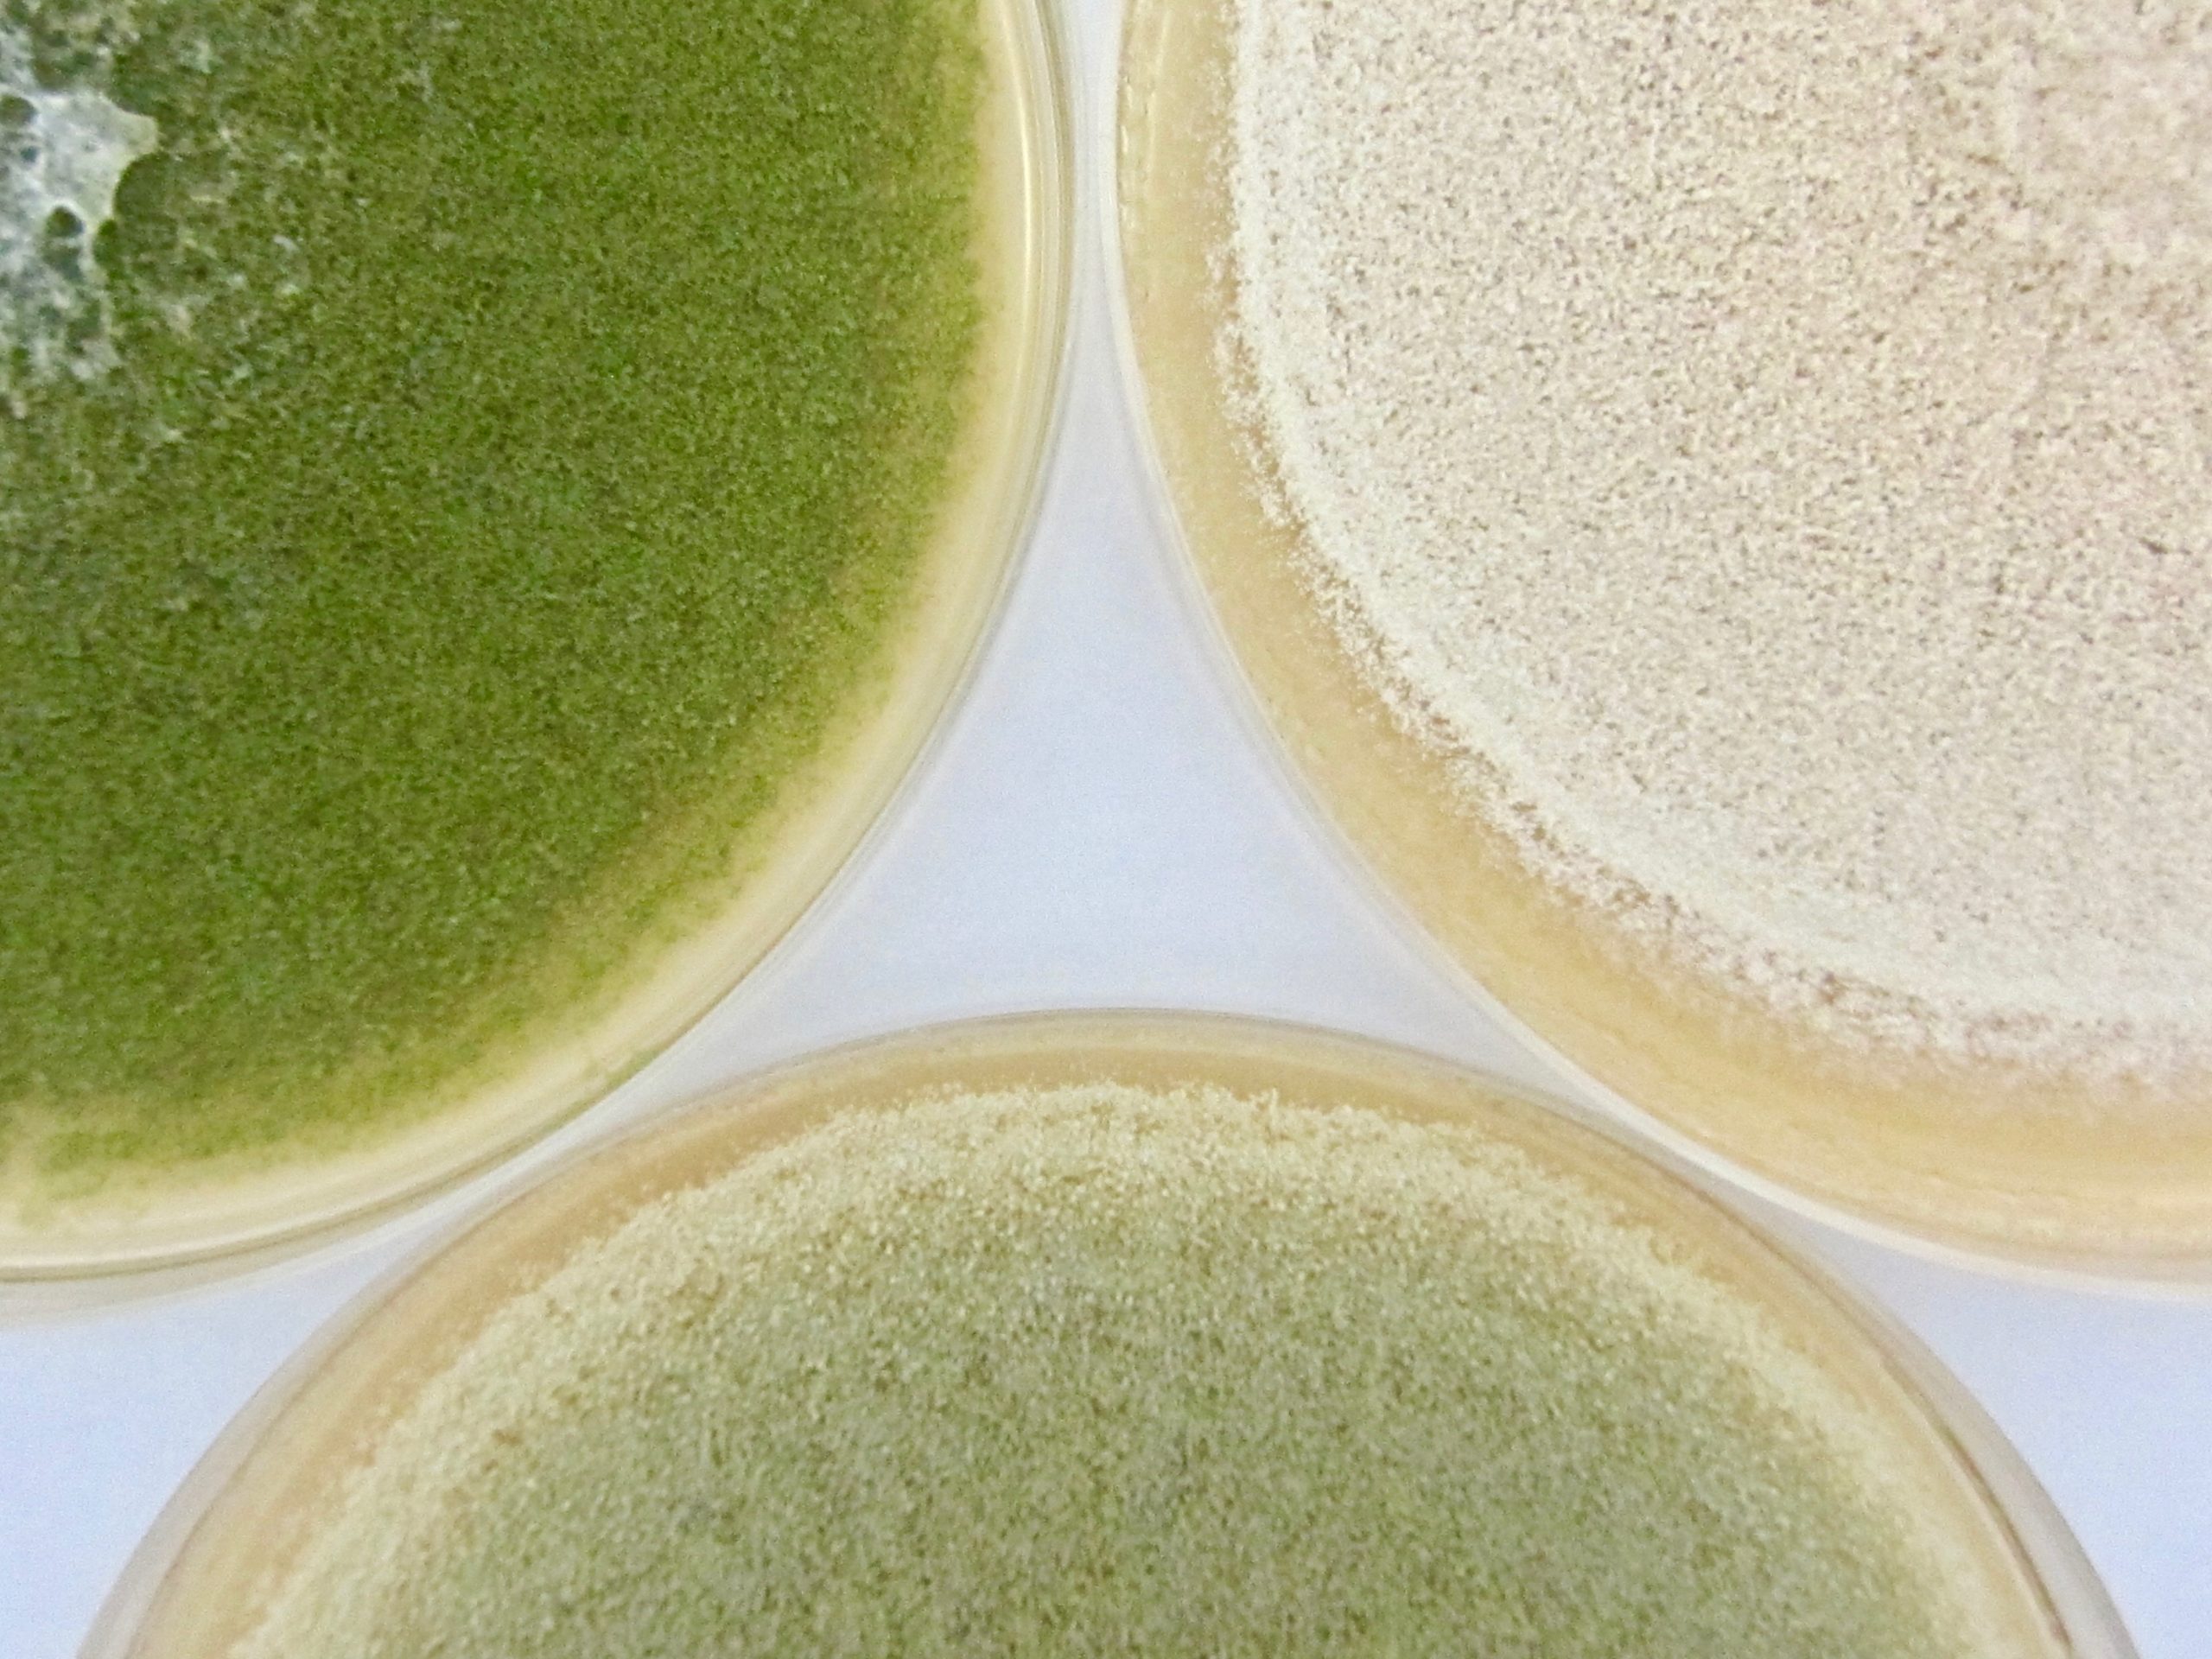

QUI SOMMES NOUS?
Nous sommes des spécialistes de l’identification des moisissures se développant dans les aliments ou dans l’environnement.
Notre expertise permet de comprendre les mécanismes de contamination et de développement des moisissures et d’aider à la mise en place de moyens de maîtrise.
Revers de Penicillium nordicum (Yes Agar 25° 10 jours)